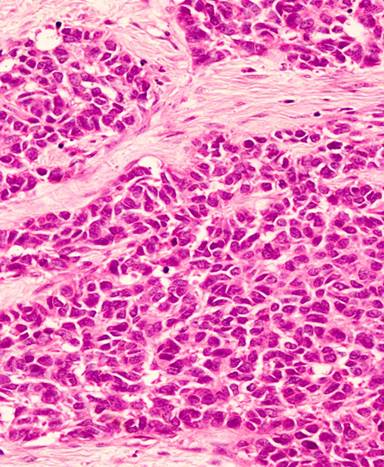

CASE REPORT
JOP. J Pancreas (Online) 2014 Nov 28; 15(6):618-621.
Pancreatic Desmoplastic Small Round Cell Tumor. A Rare Presentation of Painful Obstructive Jaundice
Duminda Subasinghe1, Chathuranga Tisara Keppetiyagama1, Hemantha Sudasinghe1, Niranthi Perera2, Thurairajah Skandarajah3, Sivasuriya Sivaganesh1
1University Surgical Unit, National Hospital of Sri Lanka; 2Department of Pathology, Faculty of Medicine, University of Colombo. Colombo, Sri Lanka. 3National Cancer Institute. Maharagama, Sri Lanka
ABSTRACT
Context Pancreatic desmoplastic small round cell tumor (DSRCT) is an extremely rare malignancy of which very few reports exist. It follows an aggressive course and has a dismal prognosis. Case report A twenty-four-year-old male presented with a one-month history of rapidly progressive obstructive jaundice associated with abdominal pain suggestive of a biliary colic. Contrast-enhanced CT (CECT) of the abdomen revealed a pancreatic head mass. He underwent a pancreaticoduodenectomy and adjuvant chemotherapy and is disease free one year after surgery. Conclusion This is the first reported case of a pancreatic head DSRCT, discovered in a young male investigated for a short history of painful obstructive jaundice.
INTRODUCTION
Desmoplastic small round cell tumors (DSRCT) originally described by Gerald and colleagues in 1989 are a group of extremely uncommon malignancies [1]. DSRCTs primarily occur in the abdominal cavity of adolescent males [2]. Although of uncertain origin, it is believed to arise from the mesothelium and is classified as a soft tissue sarcoma. No specific risk factors that have been attributed to DSRCT. It is seen predominantly in young males and has been shown to affect a multitude of organs including the abdominal cavity, small bowel mesentery, testes, ovaries and the pleura [2]. The liver and the lungs are two common sites for metastatic disease beyond the peritoneum and lymphatic spread to lymph nodes of the groin, neck and mediastinum has been described [3]. Standard treatment protocols are absent for DSCRT with evidence showing limited response to high dose chemotherapy in combination with debulking surgery and radiotherapy [4]. The prognosis for DSRCT is poor with less than 20% surviving beyond 2-3 years [5]. This is the first reported case of a patient with a pancreatic DSRCT presenting with biliary tract obstruction who underwent pancreatico-duodenectomy and adjuvant chemotherapy.
CASE REPORT
A previously well 24-year-old male presented with a one month history of rapidly progressive obstructive jaundice associated with abdominal pain suggestive of a biliary colic. He was otherwise well except for anorexia of the same duration. His past medical and family history were unremarkable except for receiving treatment for meningitis two years back. General examination revealed he was deeply icteric, but free of supraclavicular lymphadenopathy and features of chronic liver disease. Abdominal examination showed tender hepatomegaly with a palpable gallbladder but no free fluid. His liver functions were deranged with significantly elevated serum bilirubin and alkaline phosphatase levels. Trans-abdominal ultrasonography showed a suspicious pancreatic head mass, a dilated common bile duct (1.8 cm) and a distended gallbladder with no calculi. Contrast-enhanced CT (CECT) of the abdomen revealed a pancreatic head mass encircling the main pancreatic duct and CBD opening. Tumor also extending into the duodenal wall through muscularis propria without evidence of superior mesenteric or portal vessel involvement nor distal metastases. The pancreatic duct showed significant dilatation but there was no intraductal parenchymal calcification (Figures 1 and 2). These findings were corroborated by upper gastrointestinal endosonography. Pre-operative ERCP and stenting was done for nutritional optimization prior to surgery. Based on a preoperative diagnosis of an ampullary malignant stricture a standard pancreaticoduodenectomy (Whipple’s procedure) was performed. During surgery, the entire pancreas was found to exhibit a hard texture but there was no evidence of peritoneal or liver metastases. Postoperative recovery was uneventful except for a minor (ISGPF – grade A) pancreatic fistula which resolved with conservative management. The resected specimen (Figure 3) showed an irregular, solid, whitish mass measuring 4.4x3.0x3.0 cm. Histology demonstrated a lesion composed of nests of small round cells with scanty cytoplasm surrounded by prominent desmoplastic stroma, compatible with a poorly differentiated DSRCT of the pancreatic head (Figure 4). The resection margin was positive and there was perineural and vascular invasion. The tumor cells were negative for synaptophysin and chromogranin but positive for desmin and cytokeratin (Figure 5). Peripancreatic lymph nodes were positive for the tumor deposits. He received adjuvant combination chemotherapy that included vincristine, cyclophosphamide, doxorubicin, ifosfamide and etoposide. Clinical assessment and CECT done six months after surgery showed him to be well with no evidence of disease progression.

|
Figure 1. Upper GI endoscopic ultrasound showing pancreatic head mass. |

|
Figure 2. CECT abdomen showing pancreatic head mass with dilated main pancreatic duct. |

|
Figure 3. Resected surgical specimen with the tumour. |
|
Figure 4. H&E section showing poorly differentiated tumour cells within cellular desmoplastic stroma. |

|
Figure 5. Tumor cells showing cytokeratin (left) and neurone specific enolase (right) positivity. |
DISCUSSION
DSRCTs are a rare group of rapidly progressive sarcomatous malignancies. They usually present as painful abdomino-pelvic masses. Although the commonest site of origin is the peritoneum, extraperitoneal involvement is described in locations such as the testes, ovaries, and pleura [2]. Most pancreatic neoplasms are ductal adenocarcinomas and pancreatic DSRCTs are exceptionally rare in adults with only few reported cases thus far [6-8]. Since imaging characteristics are non-specific [9], the diagnosis usually becomes apparent only on histological examination of the specimen. The microscopic appearance is characterized by tubular units and scattered clusters of neoplastic cells embedded in desmoplastic stroma. The variable differentiation exhibited by DSRCTs including epithelial, mesothelial and neuronal types makes identification difficult [10, 11] though positive immunohistochemical staining for desmin, and cytokeratin is characteristic. The management of DSRCTs is a challenge due to their locally invasive and aggressive nature. No consensus exists on treatment due to the presence of only small case series of heterogeneous patient groups. Although radical excision is the primary determinant of long term survival, advanced disease at presentation usually precludes surgery with a curative intent [12, 13]. In these circumstances, a combination of debulking surgery, chemotherapy and radiotherapy have been employed [14-17], albeit in a small number of patients.
The prognosis of patients with DSRCT is generally poor with a median survival of 17 months (range 3-72) [18, 19]. Though he appears to be disease free six months after resection, the positive resection margin portends early local recurrence and is a poor prognostic factor.
To the best of our knowledge, this is the first reported case of a pancreatic DSRCT presenting with biliary tract obstruction and treated with a pancreaticoduodenectomy. DSRCT is a diagnosis that may be considered in young patients with rapidly progressive and atypical presentations of obstructive jaundice - a high index of suspicion is required because of its rarity and the absence of typical imaging characteristics. Early radical surgery with adjuvant chemotherapy may lead to tumor regression but like other aggressive sarcomas the prognosis remains poor.
Received September 04th, 2014 – Accepted October 25th, 2014
Key words Desmoplastic Small Round Cell Tumor; Pancreas
Acknowledgement The authors acknowledge all the ward staff who took care of our patient
Conflict of interest Authors declare to have no conflict of interest
Correspondence
Sivasuriya Sivaganesh
University Surgical Unit
National Hospital of Sri Lanka
Colombo
Sri Lanka
Phone: +94-112.671.846
E-mail: siva.sivaganesh@cantab.net
1. Gerald WL, Rosai J. Case 2. Desmoplastic small cell tumor with divergent differentiation. Pediatr Pathol. 1989; 9: 177-183. [PMID: 2473463]
2. Kretschmar CS, Colbach C, Bhan I, Crombleholme TM. Desmoplastic small round cell tumor: a report of three cases and review of the literature. J Pediatr Hematol Oncol. 1996; 18: 293-8. [PMID: 8689345]
3. Jordan AH, Anderson PM. The diagnosis and management of desmoplastic small round cell tumor: a review. Current Opinion in Oncology 2011, 23: 385–389. [PMID: 21577112]
4. Talarico F, Iusco D, Negri L, Belinelli D, “Combined resection and multi-agent adjuvant chemotherapy for intraabdominal desmoplastic small round cell tumour: case report and review of the literature,” Il Giornale di Chirurgia. 2007; 28: 367–370. [PMID: 17915050]
5. Navid F, Santana VM, Billups CA et al., “Concomitant administration of vincristine, doxorubicine, cyclophosphamide, ifosfamide and etopside for high risk sarcomas,”Cancer. 2006; 106: 1846–1856. [PMID: 16541446]
6. Bismar TA, Basturk O, Gerald WL, Schwarz K, Adsay NV. Desmoplastic Small Cell Tumor in the Pancreas Am J Surg Pathol 2004; 28: 808–812. [PMID: 15166674]
7. Ryan A, Razak A, Graham J, Benson A, Rowe D, Haugk B, Verrill M. Desmoplastic small round-cell tumor of the pancreas. J Clin Oncol. 2007; 25: 1440-2. [PMID: 17416866]
8. Kim JW, Park JH, Cho HJ, Kwon JH, Koh Y, Kim SJ, Kim SH, Lee SH, et al., A Case of Desmoplastic Small Round Cell Tumor Diagnosed in a Young Female Patient. Cancer Res Treat. 2009; 41: 233-236. [PMID: 20057970]
9. Kis B, O’regan KN , Agoston A, Javery O, Jagannathan J, Ramaiya NH. Imaging of desmoplastic small round cell tumour in adults. The British Journal of Radiology.2012; 5: 187–192. [PMID: 22128126]
10. Layfield LJ, Lenarsky C. Desmoplastic small cell tumors of the peritoneum coexpressing mesenchymal and epithelial markers. Am J Clin Pathol. 1991; 96: 536-43. [PMID: 1716417]
11. Norton J, Monaghan P, Carter RL. Intra-abdominal desmoplastic small cell tumor with divergent differentiation. Histopathology. 1991; 19: 560-2. [PMID: 1786939]
12. Hassan I, Shyyan R, Donohue JH, et al. Intraabdominal desmoplastic small round cell tumors: a diagnostic and therapeutic challenge. Cancer. 2005; 104: 1264-1270. [PMID: 16080179]
13. Gil A, Gomez Portilla A, Brun EA, Sugarbaker PH. Clinical perspective on desmoplastic small round-cell tumor. Oncology. 2004; 67: 231-242. [PMID: 15557784]
14. Farhat F, Culine S, Lhomme C, Duvillard P, Soulie P, Michel G, et al. Desmoplastic small round cell tumors: results of a four-drug chemotherapy regimen in five adult patients. Cancer. 1996; 77: 1363-6. [PMID: 8608516]
15. Goodman KA, Wolden SL, La Quaglia MP, Kushner BH. Whole abdominopelvic radiotherapy for desmoplastic small round-cell tumor. Int J Radiat Oncol Biol Phys. 2002; 54: 170-6. [PMID: 12182988]
16. Bertuzzi A, Castagna L, Nozza A, Quagliuolo V, Siracusano L, Balzarotti M, et al. Highdose chemotherapy in poor-prognosis adult small round-cell tumors: clinical and molecular results from a prospective study. J Clin Oncol. 2002; 20: 2181-8. [PMID: 11956280]
17. Bertuzzi A, Castagna L, Quagliuolo V, Ginanni V, Compasso S, Magagnoli M, et al. Prospective study of high-dose chemotherapy and autologous peripheral stem cell transplantation in adult patients with advanced desmoplastic small round-cell tumour. Br J Cancer. 2003; 89: 1159-61. [PMID: 14520438]
18. Kushner BH, LaQuaglia MP, Wollner N, Meyers PA, Lindsley KL, Ghavimi F, et al. Desmoplastic small round-cell tumor: prolonged progression-free survival with aggressive multimodality therapy. J Clin Oncol. 1996; 14: 1526-31. [PMID: 8622067]
19. Wong HH, Hatcher HM, Benson C, Al-Muderis O, Horan G, Fisher C, Earl HM, Judson I. Desmoplastic small round cell tumour: characteristics and prognostic factors of 41 patients and review of the literature. Clin Sarcoma Res. 2013; 26; 3: 14. [PMID: 24280007]